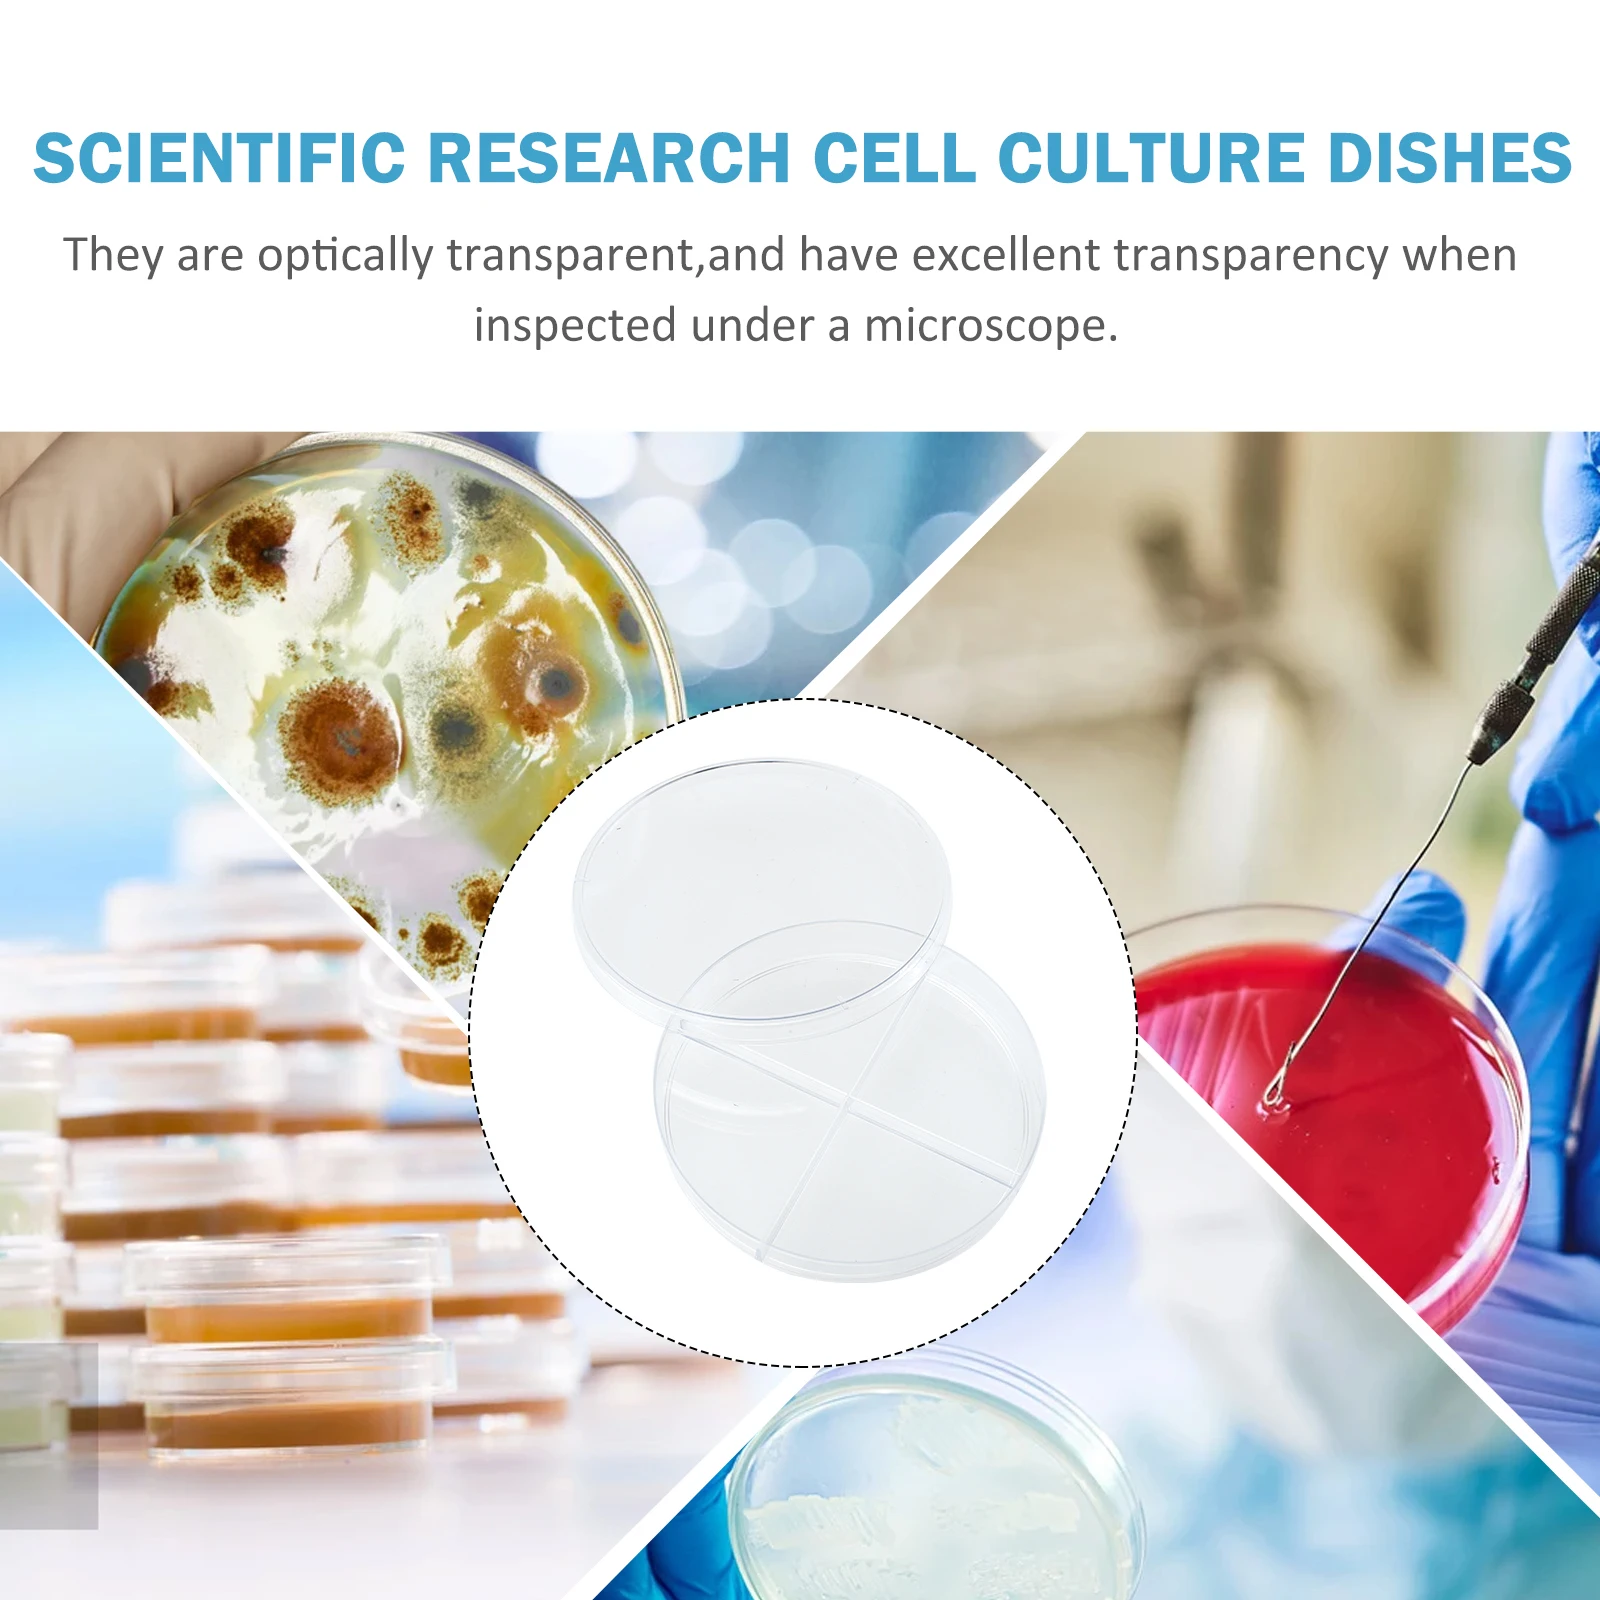

Тапочки со свинкой Пеппой Crocs, розовый
Description
Бренд: Crocs Цвет: розовый Crocs Classic Peppa Pig — детские тапочки, которые станут любимой частью обуви вашего малыша, независимо от того, играет ли он на пляже или наслаждается повседневными играми. Тапочки изготовлены из качественных материалов, обеспечивающих комфорт, стабильность и долговечность. Они изготовлены из материала крослит, который устойчив к износу и не теряет свою форму с течением времени. Все это наглядно показывает, что ваши тапочки Crocs смогут прослужить и оставаться в хорошем состоянии даже после длительного использования. Ваш малыш может носить их на пляже, в воде, по делам или даже как часть своего повседневного образа. Интересный принт с мотивами Свинки Пеппы сделает эту обувь любимой обувью вашего ребенка. Спецификация: Детские тапочки.
Technical Details
| Weight: | 160 |
Price history chart & currency exchange rate
Customers also viewed

5,156.54 руб.
Men's Jumpsuit Spring And Summer New Korean Version Of Japanese Retro Hip Hop Street Fashion Youth Leisure Loose Large Jumpsuit
aliexpress.com
1,706.57 руб.
Платье для девочек, Новинка лета 2022, Корейская версия, детское платье, розовое платье принцессы с пышными рукавами и цветами, детская одежда
aliexpress.ru
294.02 руб.
Сексуальное белье. Эротический комплект. Пеньюар. Халат (42 размер размер S) белый
prom.ua516.79 руб.
Чехол Silicone Case Full without Logo (A) для Apple iPad Pro 12.9" (2020, Сиреневый / elegant purple
prom.ua
3,127.18 руб.
100% SWISS ORIGINAL • Нож Victorinox EvoGrip Delemont 2.3903.C (аналог Wenger 1.14.09.821)
prom.ua
1,587.33 руб.
Автомобильный коврик Eva для Hyundai Santa Fe 2013-2018 Krossover, Хюндай Санта Фе Кроссовер 2 передних коврика
prom.ua
4,132.23 руб.
Подлокотник Fiat Grande Punto 2005+ Botec черный винил/Подлокотник Фиат Гранде Пунто 2005+ черный винил
prom.ua
12,764.21 руб.
Штатная магнитола для Audi A6 (4B) 1997-2005 PHANTOM DVA-7133A без поддержки мульти руля
prom.ua534.41 руб.
Чехол Silicone Case Full Protective (AA) для Apple iPhone 7 plus / 8 plus (5.5"), Оранжевый / grapefruit
prom.ua
188.25 руб.
5pcs Antler Shape Headdress Cute Comfortable Kids Gifts Special Day Christmas Party Supplies Creative Headwear Hair Hoops
aliexpress.com
865.15 руб.
Pohutukawa Pride T-Shirt custom t-shirts basketball graphic tees cotton man t-shirts tshirts personalised men clothes
aliexpress.com
336.40 руб.
Wall Shelf Dinosaur Storage Rack Hanging Bookshelf Shelves for Bedroom Kids White Cute
aliexpress.com
615.51 руб.
Retro Industrial Style Climbing Man Resin Figurine Wall Decor Home Bar Living Room Background Art Hanging Ornament
aliexpress.com
143.24 руб.
10 Pcs Bookmark Protective Cover Sleeves Organizer Pouch Accessory Pvc Holder Protectors Office Clear Bags
aliexpress.com
59,689.04 руб.
STLF WJW CJM 2022 New EU Warehouse M4 Pro 15Ah 800w Adult off Road Electric Scooters with Dropshipping
aliexpress.com